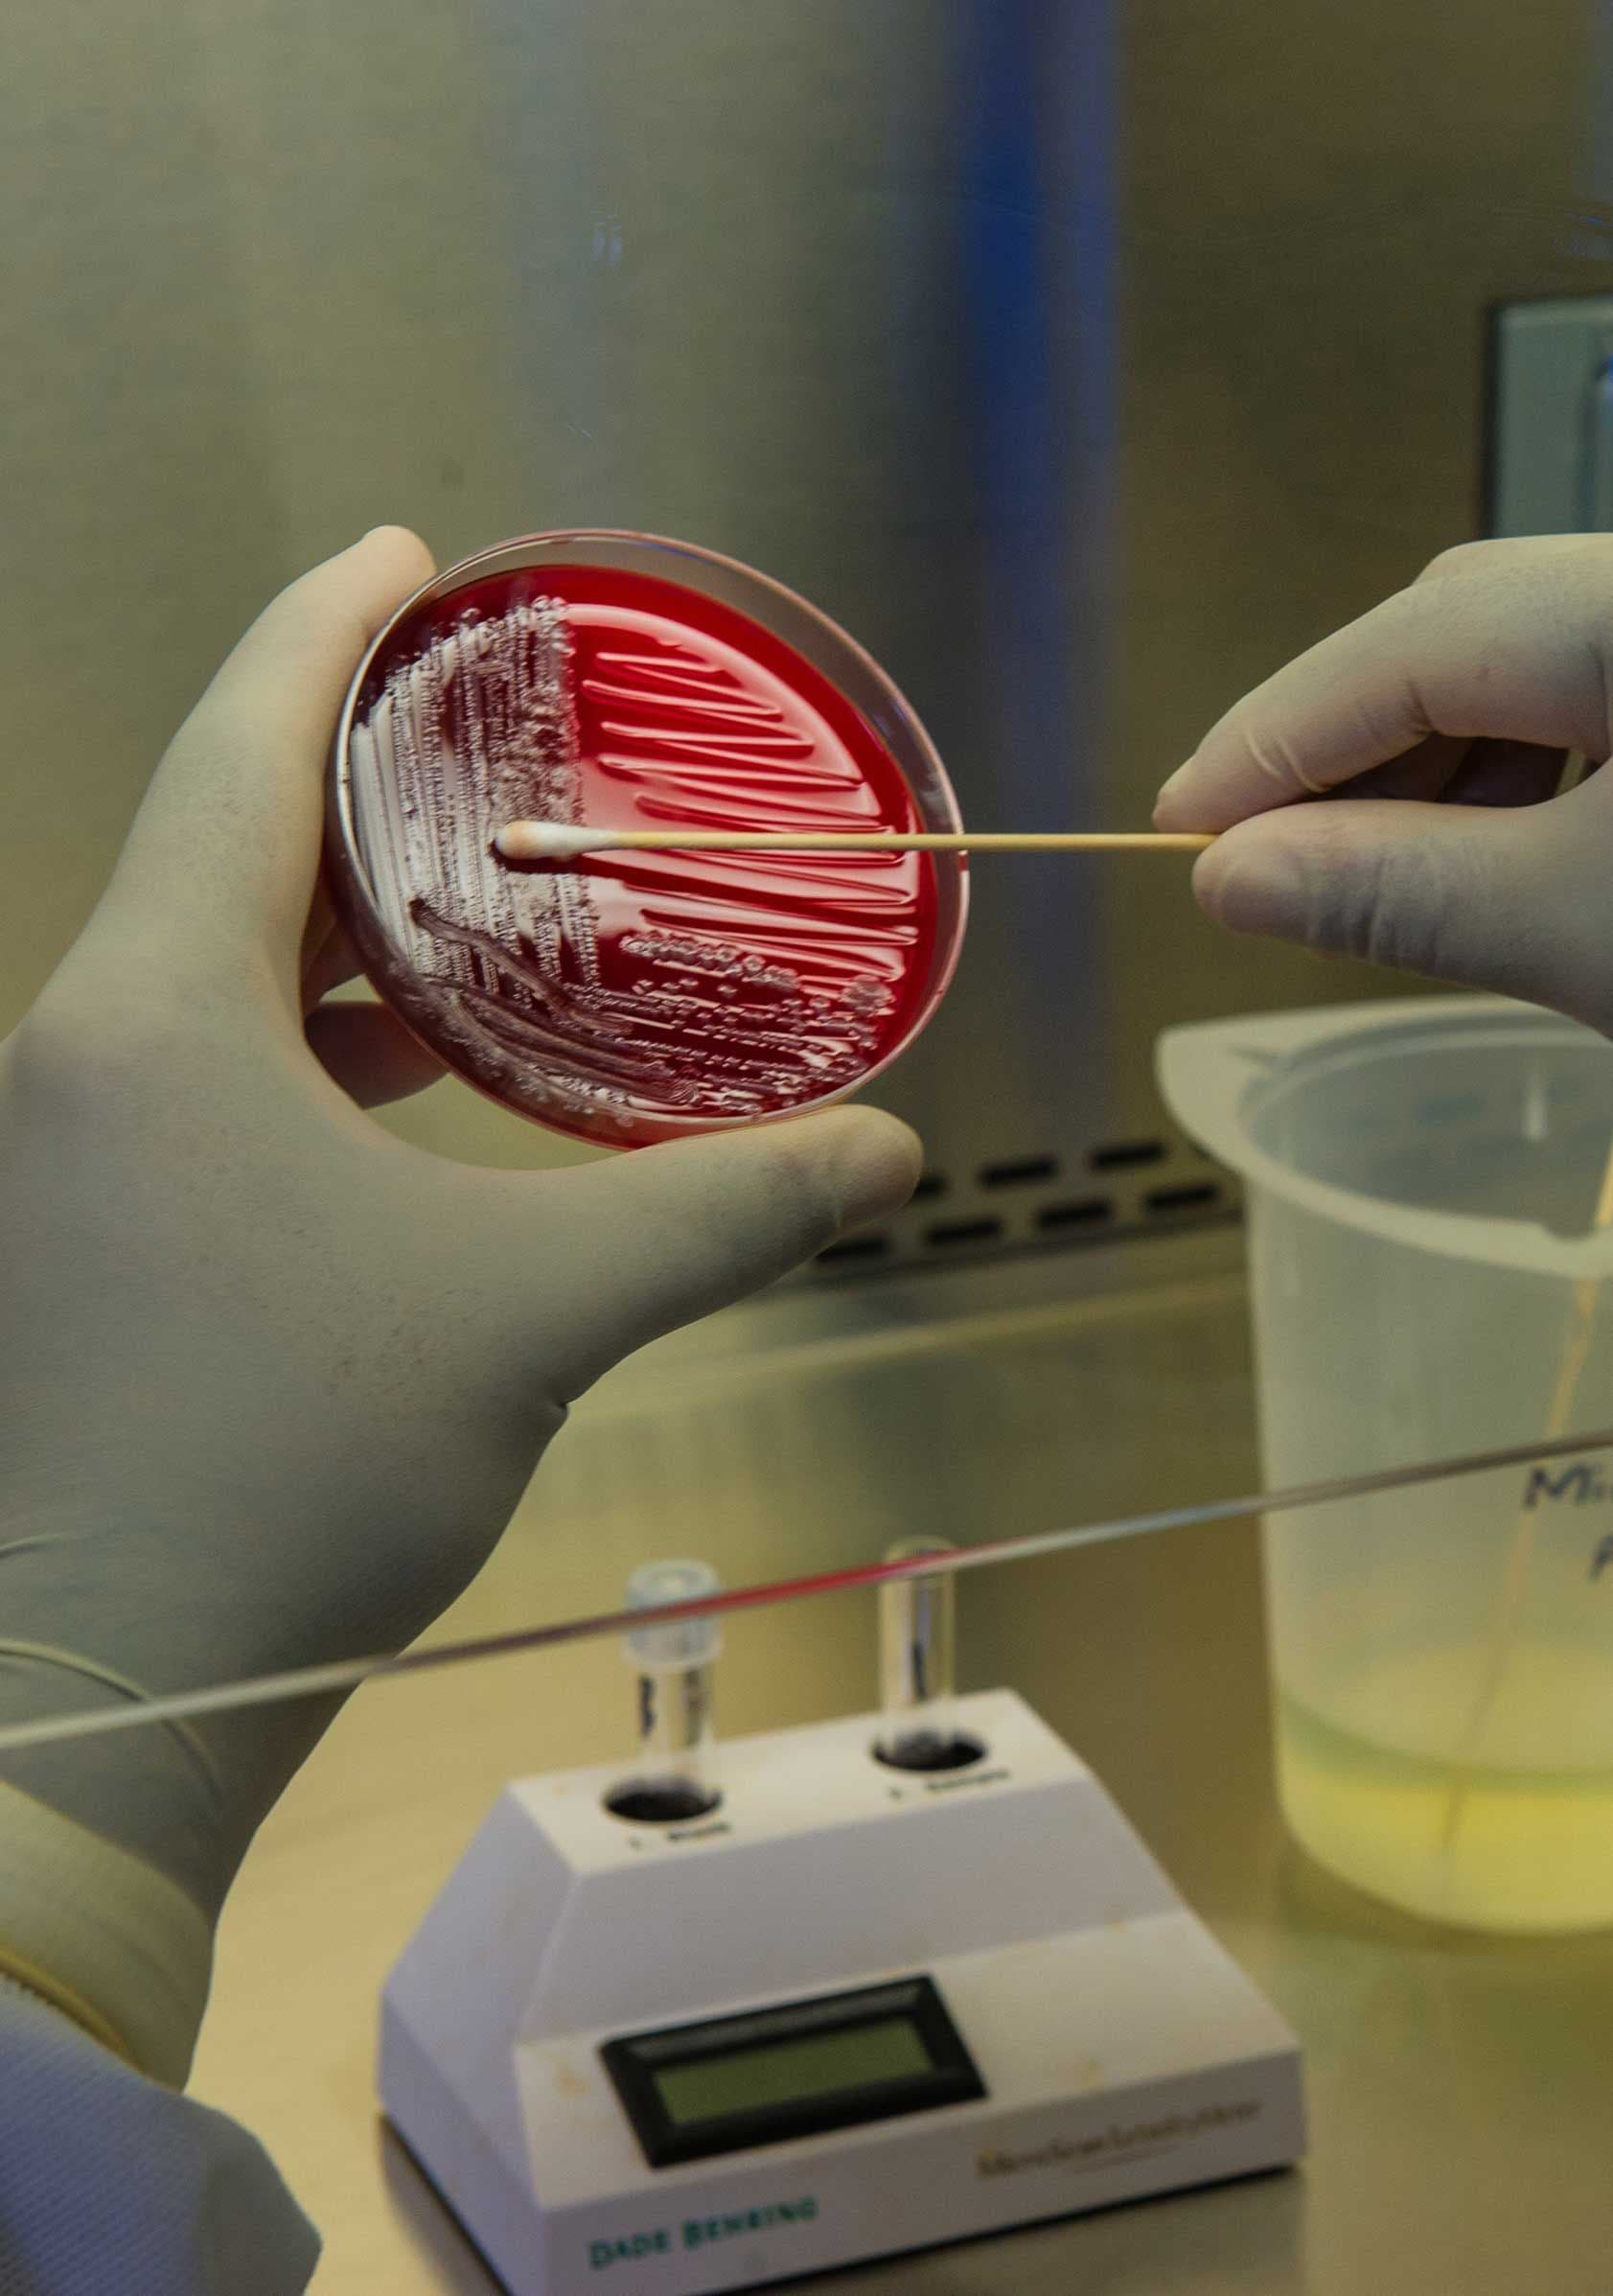
Lab culture work – a petri dish being handled in a sterile environment, representing strain engineering and quality control

1. MicBeads are derived from microbial cellulose. Could you elaborate on how their structural properties compare to traditional microplastics like PMMA or Nylon 12 in terms of particle uniformity and sensory performance in cosmetic formulations?
MicBeads 100 offers a sustainable and high-performance alternative to traditional microplastics such as PMMA and Nylon-12. Specifically, MicBeads B100 HS features a sharp particle size distribution ensuring consistent performance across formulations. This precise sizing enhances smooth spreading and uniform distribution on the skin.
In terms of sensory performance, MicBeads elevate the overall user experience in cosmetic applications. They impart a soft, velvety touch while effectively reducing tackiness and greasiness. Their oil and water absorption properties contribute to a desirable mattifying or soft-focus effect, improving skin appearance and delivering a rich, smooth texture.

2. Your fermentation process utilizes agricultural and food waste. What specific feedstocks have proven most effective in optimizing microbial cellulose yield, and how do they influence the functional properties of the final material?
BIOWEG’s microbial cellulose fermentation process can be significantly enhanced using agro- and food-waste feedstocks, particularly those rich in sugars and micronutrients. Among the most effective substrates are molasses derived from sugar beet processing, as well as liquid sidestreams generated during starch production. These feedstocks not only impact yield but also affect the final material’s crystallinity, water-holding capacity, surface chemistry, and sensorial properties like smell, colour, and texture.
3. RheoWeg serves as a biodegradable rheology modifier. How does its performance in terms of pH stability and viscosity range compare to conventional acrylic-based thickeners across various cosmetic applications?
RheoWeg exhibits pH stability, performing effectively across a broad pH range of 4 to 12. This makes it highly versatile for use in diverse cosmetic applications, from acidic exfoliating treatments to alkaline hair care products. In contrast, traditional acrylic-based thickeners often require neutralization to activate their thickening properties and are typically stable in a more limited pH range, restricting their use in more extreme formulations.
RheoWeg is a highly stable, biodegradable rheology modifier that offers performance and sustainability for a wide range of cosmetic applications. It functions both as a thickener and an effective suspending agent, making it ideal for formulating stable, visually appealing products.
RheoWeg allows formulators to tailor viscosity across a broad spectrum—from light serums and lotions to rich creams, structured gels, and shampoos. By adjusting its concentration, it acts as a gellifying agent or a viscosity builder.
RheoWeg offers stable, shear-thinning behavior with excellent spreadability and sensory aesthetics. It avoids the tackiness sometimes associated with synthetic thickeners and supports a more natural, smooth skin feel.

4. HydroWeg is positioned as a clean-label hydrocolloid for plant-based foods. What are its gelling and emulsifying properties compared to traditional hydrocolloids like gelatin or carrageenan, particularly in meat and dairy alternatives?
HydroWeg, a clean-label hydrocolloid based on bacterial cellulose, offers excellent water-binding, oil-binding, and emulsion-stabilizing properties, making it highly suitable for plant-based meat and dairy alternatives. It forms soft, stable gels and provides a fibrous texture that enhances structure and juiciness in meat analogs. Compared to gelatin and carrageenan, HydroWeg delivers superior moisture retention, good lipid compatibility, and effective binding of oils and fats, contributing to stable, homogeneous formulations. Its non-animal origin and allergen-free profile make it ideal for clean-label, vegan applications where both functionality and consumer acceptance are critical. Last but not least, bacterial cellulose is a pure, non-soluble fibre which helps in increasing the fiber profile of a given food or beverage product.
5. AgriWeg offers a biodegradable solution for seed and fertilizer coatings. How does its tunable release profile and dust formation compare to traditional petroleum-based coatings in agricultural applications?
AgriWeg, developed using polycarbohydrates and based on suspo-emulsion technology, offers a fully biobased and biodegradable alternative to traditional petroleum-based seed and fertilizer coatings, which are non-biodegradable and less eco-friendly. Its hydrophobic content imparts water resistance, while the polycarbohydrate matrix forms a cohesive film over the substrate, preventing immediate disintegration and enabling a tunable, controlled release of nutrients.
The combination of hydrophobes and polycarbohydrates in AgriWeg creates capillary channels that facilitate slower diffusion of fertilizers into the soil, effectively reducing nutrient loss. The polycarbohydrates also help to increase the hardness of fertilizer and reduce dust formation during storage.

6. Your products are customizable in terms of size, shape, and texture. What methodologies do you employ to tailor these parameters, and how do they impact the performance and application of the materials?
Our products are customizable in terms of size, shape, and texture, and we have optimized our processes to consistently achieve the desired outcomes. We employ a range of advanced milling and grinding techniques to tailor these parameters with precision. These processes are carried out in a controlled environment to ensure material integrity. It's important to note that improper or unoptimized processing can negatively affect the properties of the materials, which is why our approach emphasizes precision and consistency at every stage.
7. The biodegradation of your materials is a key feature. Could you provide details on the degradation timeline and conditions required, and how these align with current environmental regulations?
BIOWEG’s microbial cellulose-based materials, such as MB100 micropowders, RheoWeg rheology modifiers, and biobased formulations like AgriWeg, are fully biodegradable under natural conditions, meeting key international standards. We have third-party validated reports which confirm the biodegradability as per regulations defined under OECD 301 Series: Ready Biodegradability Test standards.
8. Surface functionalization is crucial for material performance. What green chemistry approaches do you utilize to modify the surface properties of microbial cellulose, and how do these modifications enhance functionality?
We utilize controlled surface oxidation techniques, aligned with green chemistry principles, to modify the surface properties of microbial cellulose. This approach enhances the structural characteristics of the material, allowing us to tailor its rheology for optimal performance in personal care applications. As a result, the modified cellulose not only meets functional requirements but also delivers excellent sensory and stability qualities.

9. Collaborations are integral to your development process. How have partnerships, such as with Bayer, influenced the scalability and application of your biodegradable materials in various industries?
Collaborations, particularly with industry leaders, have been pivotal in accelerating the development, scalability, and market alignment of BIOWEG’s biodegradable materials. Through joint development agreements (JDAs) and application-specific testing, partners have provided valuable insights into performance benchmarks, regulatory requirements, and formulation needs for various applications. This has enabled BIOWEG to refine product properties such as particle size, texture, rheology, and biodegradability to meet stringent standards.
These collaborations also support scalability by offering early validation, off-take potential, and feedback loops essential for aligning pilot-scale processes with industrial demand. Moreover, working with global players opens access to broader markets—ranging from skincare, haircare, home care, food, and agriculture —while enhancing BIOWEG’s credibility with other partners, regulatory bodies, and investors. Such partnerships have not only accelerated product refinement but also de-risked commercialization by ensuring alignment with real-world application and sustainability targets.
10. Your commitment to sustainability includes utilizing sidestreams as feedstocks. How does this approach contribute to a circular economy, and what challenges have you encountered in sourcing and processing these materials?
BIOWEG’s use of sidestreams from the sugar-starch industry as feedstocks directly supports a circular economy by transforming organic low-value items into high-value, biodegradable materials. This approach reduces dependency on virgin raw materials, lowers carbon footprint, and diverts biomass from landfills or incineration, thereby closing resource loops. It aligns with EU Green Deal objectives and SDG 12 (responsible consumption and production), enabling upcycling of local biomass into functional ingredients for cosmetics, home care, food, and agriculture.
However, this model comes with challenges. Sourcing consistent-quality sidestreams requires close collaboration with food and agriculture partners, and contamination can affect yield and process efficiency. Additionally, preprocessing steps—such as filtration, hydrolysis, or sterilisation—must be tailored to each sidestream, increasing operational complexity. Despite these hurdles, BIOWEG continues to work with regional suppliers and research partners to stabilize supply chains and scale sustainable, circular inputs into industrial fermentation processes.

11. What advancements do you foresee in the development of bio-based materials, and how is Bioweg positioned to lead in replacing non-degradable polymers across various sectors?
The future of bio-based materials is moving rapidly toward multifunctional, high-performance solutions that are scalable, sustainable, and compete head-on with synthetic-derived ones. Key advancements will include the integration of green chemistry-derived engineered functionalities, precision fermentation for tailored material properties, and AI-driven optimization of both feedstock inputs and microbial production pathways. Regulatory shifts, such as the EU’s microplastic ban and global demand for ESG-compliant ingredients, are accelerating adoption across cosmetics, home care, packaging, and agriculture.
BIOWEG is uniquely positioned to lead this transformation. With a proprietary fermentation platform that leverages sidestreams, a strong IP portfolio, and strategic collaborations with global players, the company is bridging the gap between laboratory innovation and industrial application. BIOWEG’s materials are designed not only to be biodegradable but to outperform conventional polymers in functionality—be it texture, stability, or sensory experience. By focusing on modular, scalable production and product platforms (such as MB100, RheoWeg, HydroWeg, AgriWeg), BIOWEG is building a next-generation bio-based toolkit to replace petroleum-derived polymers across multiple sectors.








